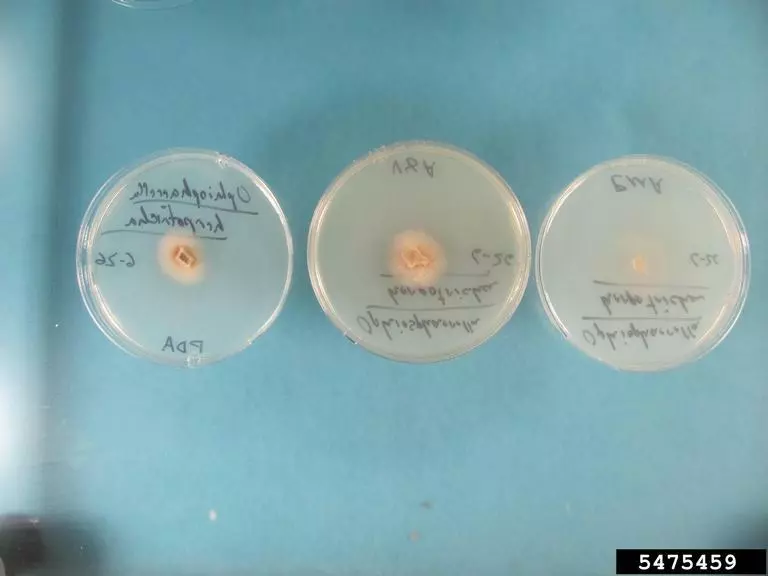
54

Справочники у вас в кармане! Больше не нужно листать десятки сайтов.
Устали искать актуальную информацию по препаратам? GOLD решает это!
Наша нейросеть gEPA сделала для вас: собрала информацию, проверила и структурировала данные в удобные справочники по пестицидам, удобрениям и семенам.
Можно подобрать по названию, культуре, действующему веществу или вредителю — всегда быстро и точно.
Всё работает даже без интернета и постоянно обновляется. Сохраняйте данные из справочников прямо в свои заметки и дополняйте своими исследованиями!
Оформите GOLD и получите доступ к базе знаний 24/7.
Устали искать актуальную информацию по препаратам? GOLD решает это!
Наша нейросеть gEPA сделала для вас: собрала информацию, проверила и структурировала данные в удобные справочники по пестицидам, удобрениям и семенам.
Можно подобрать по названию, культуре, действующему веществу или вредителю — всегда быстро и точно.
Всё работает даже без интернета и постоянно обновляется. Сохраняйте данные из справочников прямо в свои заметки и дополняйте своими исследованиями!
Оформите GOLD и получите доступ к базе знаний 24/7.